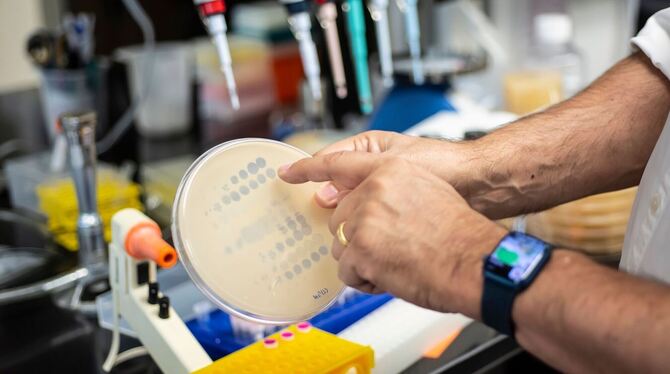
Phagentherapie

Manchem mag es riskant erscheinen, Viren gezielt in Wunden zu reiben, einzuatmen, zu schlucken oder gar in die Blutbahn zu spritzen. Doch bei der sogenannten Phagentherapie kommen tatsächlich bakterienfressende, für den Menschen ungefährliche Viren zum Einsatz.
Mit der steigenden Zahl von Antibiotikaresistenzen wird dieser lange kaum noch verwendeten Therapieform wieder mehr Aufmerksamkeit zuteil. Aber ist sie die Lösung für die große Krise der Medizin? Zwei große deutsche Projekte stehen kurz davor, Patienten zu behandeln.
Bakteriophagen sind ständig um und in uns. Ein erwachsener Mensch bestehe aus etwa 30 Billionen Körperzellen, 40 Billionen Bakterien - und 300 Billionen Phagen, sagt Phagentherapie-Experte Christian Willy, Direktor der Klinik für Unfallchirurgie am Bundeswehrkrankenhaus Berlin. Bakteriophagen sind Viren, die in Bakterien Vermehrungsprogramme in Gang setzen, bis die Masse neu produzierter Viren die Bakterienzelle zum Platzen bringt. Bakterienansammlungen etwa in einem Entzündungsherd können so rasch verschwinden.
Meilenstein in Sicht
Eines der Projekte, bei dem bald Patienten behandelt werden sollen, ist »Phage4Cure«, bei dem eine Therapie mit inhalierbaren Phagen gegen den gefürchteten Krankenhauskeim Pseudomonas aeruginosa entwickelt wird. Oft besiedelt der Erreger die Lunge von Mukoviszidose-Patienten. Im Spätsommer soll es mit einer klinischen Phase-I-Studie zur grundsätzlichen Verträglichkeit losgehen, wie Christine Rohde am Leibniz-Institut DSMZ (Deutsche Sammlung von Mikroorganismen und Zellkulturen GmbH) in Braunschweig sagt. Anders als meist üblich gebe es direkt auch eine Kohorte mit Patienten. »Wenn die Phase I erfolgreich läuft und es den Patienten besser geht, dann ist ein echter Meilenstein für die Phagentherapie in Deutschland erreicht.«
Vereinzelt werden in Deutschland bereits Patienten behandelt, bei denen die verfügbaren zugelassenen Therapien keine Wirkung zeigen. Zum Beispiel von Christian Kühn, Leiter des Nationalen Phagenzentrums der Medizinischen Hochschule Hannover. »Ich sehe tagtäglich, was Antibiotika-Resistenzen anrichten«, betont der Mediziner. »Wir brauchen Alternativen.« Mehr als 30 Patienten wurden in Hannover bereits behandelt, oft gegen Staphylococcus aureus, ein Bakterium, das hartnäckige Wundinfektionen verursachen kann.
Auf die dabei genutzte individuelle Herstellung jeweils für den einzelnen Patienten - magistrale Anwendung genannt - setzt auch das zweite große deutsche Vorhaben, das von der Klinik für Unfallchirurgie am Bundeswehrkrankenhaus Berlin durchgeführte Projekt »PhagoFlow«. Während es bei »Phage4Cure« um ein Krankheitsbild, einen Erreger und eine verabreichte Mixtur geht, sollen im Zuge von »PhagoFlow« unterschiedliche und auf verschiedene Erreger zurückgehende Krankheitsbilder behandelt werden, wie Projektleiter Willy erklärt. Ab der zweiten Jahreshälfte könnten erste Patienten behandelt werden, hofft er.
Länger bekannt als Penicillin
Schon seit etwa einem Jahrhundert werden Bakteriophagen als Mittel gegen Infektionen eingesetzt. Entdeckt wurden sie gut zehn Jahre bevor der schottische Bakterienforscher Alexander Fleming 1928 die antibiotische Wirkung des Penicillins herausfand.
Ein großer Unterschied beider Bakterien-Killer: Während Antibiotika eher wie eine Massenvernichtungswaffe funktionieren, sind Phagen Auftragsmörder mit ganz bestimmtem Ziel. Sie befallen jeweils nur eine Bakterienart, sehr häufig sogar nur einen bestimmten Stamm einer Art. Das macht die Nutzung kompliziert: Für die jeweiligen Bakterienstämme eines Patienten muss zunächst der passende Phage gefunden werden. »Und meist spielt bei einer kritischen Infektion mehr als ein Stamm eine Rolle«, erklärt Holger Ziehr, Leiter der Pharmazeutischen Biotechnologie am Fraunhofer-Institut für Toxikologie und Experimentelle Medizin (ITEM).
Doch wo findet man passende Phagen, um einen bestimmten Erreger zu bekämpfen? Oft wählen Experten dafür eine ganz einfache Quelle: »Abwasser«, sagt der Phagenforscher Alexander Harms vom Biozentrum der Universität Basel. Auf Nährplatten werden zunächst die Bakterien gezüchtet, gegen die man Phagen einsetzen möchte. Auf den Bakterienrasen kommt die Wasserprobe. Ist ein das Bakterium tötender Phage dabei, entsteht ein Loch im Bakterienrasen - aus dieser Stelle wird das Virus isoliert und im Labor vermehrt.
Ersatz für Antibiotika
Viel mehr Aufwand also, als eine gegen viele Erreger wirkende Pille aus der Schublade zu holen. Doch die Wunderwaffe Antibiotika droht stumpf zu werden. Mehr als 30.000 Todesfälle gehen in der EU nach Schätzungen jährlich auf antibiotikaresistente Bakterien zurück. Rund 700.000 sind es nach Schätzungen weltweit. Tendenz steigend. Kann die Phagentherapie Abhilfe schaffen?
In den Ostblockstaaten - wo es zunächst keinen breiten Zugang zu Antibiotika gab - wurden weiter häufig Phagen genutzt. Bis heute sind Institutionen aus solchen Ländern weltweit führend, allen voran das Georgi-Eliava-Institut in Tiflis, Georgien. Andere Länder wie die USA, Belgien, Frankreich lassen die Therapieform nun wieder aufleben. Beispiele aus den USA zeigten, dass es inzwischen möglich sei, binnen 10 Tagen eine passende Phagentherapie für einen Patienten zu erstellen, sagt Christian Kühn vom Phagenzentrum in Hannover.
Überzeugende Ergebnisse zur Effizienz von Phagen in sehr großen klinischen Studien, wie sie in der Arzneimittelforschung zum geforderten Standard geworden sind, gibt es zu den oft nur individualisiert einsetzbaren Phagen bisher nicht, wie Phagen-Expertin Christine Rohde sagt. Einzelfallberichte und kleinere Studien zeigen beeindruckende Erfolge, wie die deutschen Experten erzählen.
In einer kürzlich vorgestellten Studie wurden 20 Patienten mit hartnäckigen bakteriellen Infektionen mit Bakteriophagen behandelt. Bei elf Patienten sei die Therapie erfolgreich verlaufen, berichteten die Forschenden im Fachblatt »Clinical Infectious Diseases«. Nebenwirkungen traten demnach nicht auf. Ziehr verweist auf das heterogene Teilnehmerkollektiv, zu dem Kinder wie auch Erwachsene mit diversen Krankheitsbildern, komplexen Infektionen und unterschiedlichen Erregertypen zählten. Dass angesichts dieser Umstände mehr als die Hälfte der Teilnehmer auf die Therapie angesprochen habe, sei beeindruckend, sagt der Experte, der nicht an der Arbeit beteiligt war.
Komplett ersetzen werden Bakteriophagen die Antibiotika nicht, wie die Experten betonen. Ein vielversprechender Weg könnte vor allem die Kombination von Bakteriophagen und Antibiotika sein, basierend auf der sogenannten Phagen-Antibiotika-Synergie (PAS), erklärt der Berliner Phagenforscher Willy. Es habe sich gezeigt, dass resistente Bakterien bei einem Patienten wieder empfindsam gegen Antibiotika werden können, wenn dieser zuvor mit Phagen behandelt wurde.
Studie zu 20 behandelten Patienten
Studie zu Todesfällen durch antibiotikaaresistente Bakterien in der EU-Region
Fallbericht in »Cell« zur Behandlung einer Lungeninfektion mit Mycobacterium abscessus
Fallbericht im Fachmagazin »Nature«, 2019
Analyse zur Bedeutung von Phagen-Banken u.a. für ärmere Länder, Current Opinion in Virology, 2022
Startup zur in vitro-Herstellung von Phagen
© dpa-infocom, dpa:220615-99-671694/2